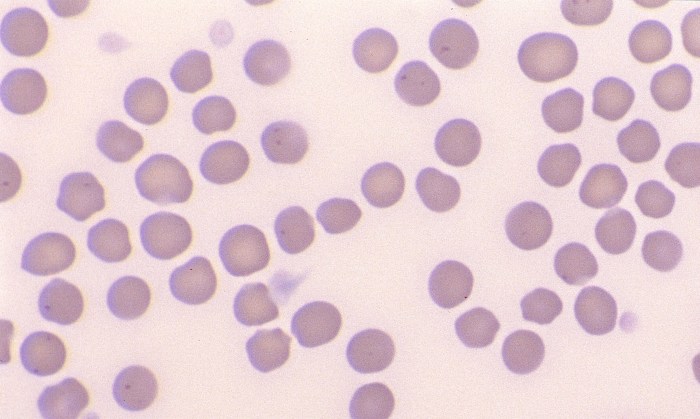
Normal Equine 2

Normal Equine Erythrocytes

Morphology: relatively small, uniform red blood cells with little to no central pallor.
Lifespan: 140 – 150 days
Other features: rouleaux may be prominent in healthy horses. Polychromatophils are not observed in blood of healthy horses and rarely observed with anemia (degree of regenerative response to anemia in horses cannot be assessed by quantifying reticulocytes). Foals (up to 1 year of age) may show microcytosis due to physiologic iron deficiency.